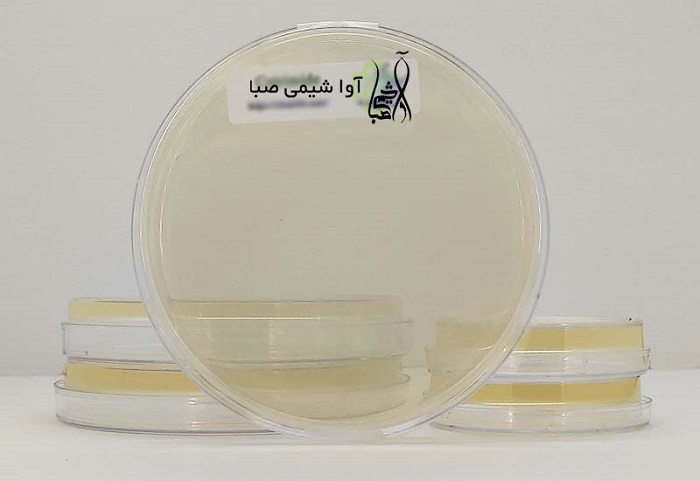
Cetrimide
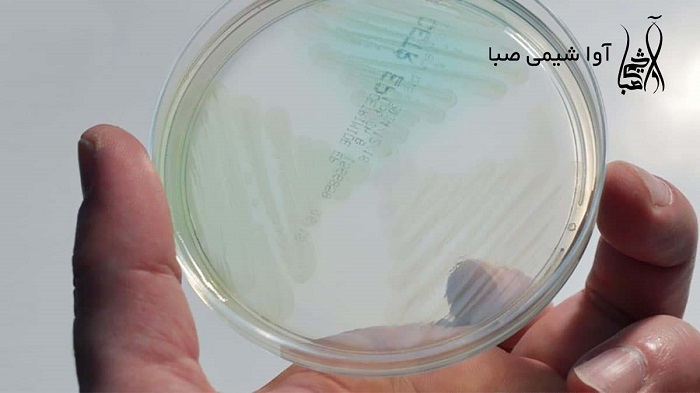
ستریماید

در دنیای امروز، بهداشت و ضدعفونی کردن یکی از مهم ترین ارکان پیشگیری از بیماری ها به شمار می رود. دو ضدعفونی کننده رایج، ساولن و الکل، انتخاب هایی محبوب در محیط های درمانی و خانگی هستند. اما هر یک از این مواد ویژگی های منحصر به فرد خود را دارند که آن ها را برای کاربردهای خاص مناسب تر می سازد. در این مقاله به بررسی تفاوت ها، مزایا و معایب این دو ماده پرداخته شده است.
ساولن چیست؟
ساولن یکی از مواد ضدعفونی کننده قوی است که از ترکیب دو ماده اصلی ستریماید سی و کلرهگزیدین دیگلوکونات تشکیل شده است. این ترکیبات به دلیل اثرگذاری بالا در از بین بردن باکتری ها، قارچ ها و ویروس ها، ساولن را به گزینه ای مناسب برای استفاده در بیمارستان ها، کلینیک ها و حتی خانه ها تبدیل کردهاند.
ستریماید سی چیست؟
ستریماید سی یک ماده فعال سطحی (سورفکتانت) است که با تخریب غشای سلولی میکروارگانیسم ها، آن ها را از بین می برد. در محصولاتی مانند ساولن از ستریماید سی 40% استفاده می شود که غلظتی استاندارد و موثر در ضدعفونی کردن محیط و پوست محسوب می شود.
الکل چیست؟
الکل یکی از ضدعفونی کننده های قدیمی و پرکاربرد است که در غلظت های مختلف (معمولاً 70%) برای از بین بردن میکروارگانیسم ها مورد استفاده قرار می گیرد. این ماده معمولاً به دو شکل اتانول و ایزوپروپانول در بازار موجود است و کاربرد آن شامل ضدعفونی دست ها، تجهیزات پزشکی و سطوح است.
مقایسه کاربردها و مزایا
- محدوده اثربخشی
ساولن: ساولن به ویژه برای از بین بردن باکتری ها و قارچ ها موثر است و در برابر برخی ویروس ها نیز عملکرد خوبی دارد. ترکیب ستریماید سی با کلرهگزیدین به این ماده خاصیت گسترده ای در مقابله با انواع میکروارگانیسم ها می بخشد.
الکل: الکل در غلظت مناسب (60-90%) به طور خاص در از بین بردن ویروس ها و باکتری ها بسیار موثر است، اما در مقابله با قارچ ها یا اسپورهای باکتریایی ممکن است محدودیت هایی داشته باشد.
- ایمنی برای پوست
ساولن: به دلیل داشتن ستریماید سی، ساولن ملایم تر از الکل است و احتمال تحریک یا خشکی پوست را کاهش می دهد.
الکل: استفاده مکرر از الکل ممکن است باعث خشکی یا تحریک پوست شود.
- ماندگاری اثر
ساولن: ساولن به دلیل ویژگی های کلرهگزیدین، اثر ماندگارتری دارد و تا چند ساعت پس از استفاده همچنان می تواند از رشد میکروارگانیسم ها جلوگیری کند.
الکل: اثر الکل کوتاه مدت است و پس از تبخیر، خاصیت ضدعفونی کنندگی آن پایان می یابد.
- کاربردهای محیطی
ساولن: به دلیل ترکیبات قوی، برای ضدعفونی محیط، ابزارهای جراحی و زخم ها ایده آل است.
الکل: بیشتر برای ضدعفونی سریع دست ها، تجهیزات کوچک و سطوح مناسب است.
مزایا و معایب ساولن و الکل
مزایای ساولن
- اثرگذاری ماندگار بر روی پوست و محیط
- ملایم تر بودن برای پوست نسبت به الکل
- قابلیت استفاده در محیط های حساس مانند زخم های باز
- مؤثر در برابر طیف گسترده ای از میکروارگانیسم ها
معایب ساولن
- نیاز به رقیق سازی صحیح برای برخی کاربردها
- ممکن است به برخی سطوح حساس آسیب برساند
- در صورت بلع یا استفاده نادرست، خطر مسمومیت دارد
مزایای الکل
- سرعت عمل بالا در ضدعفونی کردن
- تبخیر سریع و بدون باقی ماندن اثر
- قیمت پایین و در دسترس بودن
معایب الکل
- خشکی و تحریک پوست در استفاده مکرر
- خطر آتش سوزی به دلیل اشتعال پذیری بالا
- اثرگذاری محدود در برابر قارچ ها و اسپورهای باکتریایی
نکات ایمنی در استفاده از ساولن و الکل
ساولن: پیش از استفاده برای ضدعفونی زخم، ساولن را طبق دستورالعمل رقیق کنید. از تماس مستقیم با چشم ها جلوگیری کنید. ساولن را دور از دسترس کودکان نگه دارید.
الکل: هرگز الکل را در نزدیکی شعله استفاده نکنید. از تماس مستقیم الکل با زخم های باز خودداری کنید. در محیط های دارای تهویه مناسب استفاده کنید.
ساولن یا الکل؟ کدام انتخاب مناسب تر است؟
انتخاب بین ساولن و الکل به کاربرد موردنظر بستگی دارد. اگر نیاز به ضدعفونی ماندگارتر دارید یا پوست حساسی دارید، ساولن با ترکیب ستریماید سی و کلرهگزیدین گزینه بهتری است. اما اگر به ضدعفونی سریع و بدون باقی ماندن اثر نیاز دارید، الکل مناسب تر است.
خرید ستریماید سی 40% برای تولید ساولن
اگر شما تولیدکننده محصولات ضدعفونی کننده هستید و به دنبال خرید ستریماید سی 40% با کیفیت بالا برای تولید ساولن یا محصولات مشابه می گردید، انتخاب تأمین کننده معتبر اهمیت زیادی دارد. آواشیمی صبا، واردکننده مواد اولیه دارویی، غذایی، آرایشی و بهداشتی، یکی از برترین گزینه ها در تأمین ستریماید سی 40% و سایر ترکیبات موردنیاز شماست. این مجموعه محصولات خود را با استانداردهای جهانی و قیمتی رقابتی عرضه میکند.
نتیجه گیری
ساولن و الکل، هر دو ضدعفونیکننده های کارآمدی هستند، اما ویژگی ها و کاربردهای متفاوتی دارند. ساولن با ترکیباتی مانند ستریماید سی و کلرهگزیدین برای مصارف گسترده تر و ماندگارتر مناسب است، در حالی که الکل بیشتر برای ضدعفونی سریع کاربرد دارد. انتخاب بین این دو به نیاز خاص شما بستگی دارد. اگر به دنبال تهیه مواد اولیه برای تولید ساولن یا دیگر ضدعفونی کننده ها هستید، پیشنهاد می کنیم محصولات با کیفیت از آواشیمی صبا را بررسی کنید.

